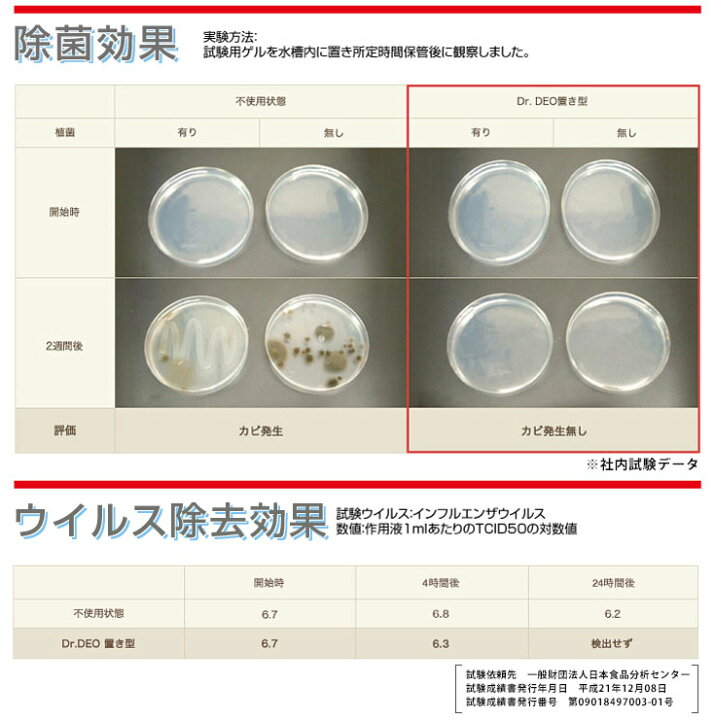
楽天市場 消臭剤 車 エアコン カーメイト D172 ドクターデオ Dr Deo エアコンスプレータイプ 無香 消臭スプレー 安定化二酸化塩素 車の強力 消臭剤 除菌 Carmate カーメイト 公式オンラインストア 楽天市場 消臭剤 車 エアコン カーメイト D172 ドクターデオ Dr Deo エアコンスプレータイプ 無香 消臭スプレー 安定化二酸化塩素 車の強力 消臭剤 除菌 Carmate カーメイト 公式オンラインストア

選択した画像 車 消臭 ドクターデオ エアコン 254179-車 消臭 ドクターデオ エアコン
ドクターデオ エアコンスプレータイプ 無香 カーメイト 車内用消臭剤 通販モノタロウ D172
カーメイト 車用 除菌消臭剤 ドクターデオ drdeo エアコン取付 詰替用 ウイルス除去 無香 安定化二酸化塩素 4g d176が車&バイクストアでいつでもお買い得。当日お急ぎ便対象商品は、当日お届け可能です。アマゾン配送商品は、通常配送無料(一部除く)。除菌・消臭スプレー オートバックス売れ筋商品! ネット販売価格 ¥1,8 (税込) おすすめ (2) ドクターデオプレミアム 置きタイプ2P D224W 2個セット 人気の「ドクターデオ」を更に消臭性能をパワーアップ! お得な2個セットです
車 消臭 ドクターデオ エアコン
車 消臭 ドクターデオ エアコン-カーメイト 車用 消臭剤 ドクターデオ エアコン専用 スプレー型 無香 安定化二酸化塩素 180ml D177が車&バイクストアでいつでもお買い得。当日お急ぎ便対象商品は、当日お届け可能です。アマゾン配送商品は、通常配送無料(一部除く)。販売価格 ¥ 1,210 本体価格 ¥ 1,100 "消毒臭"が気になりにくい、メントール配合スチームが誕生
ドクターデオプレミアム エアコン取付タイプ D222 オートバックス公式通販サイト
車の消臭剤には色々有りますが以前より試して見たかったドクターデオシリーズです。 メーカー商品説明より抜粋 ☆安心&安全な「安定化二酸化塩素」使用 ドクターデオの成分「安定化二酸化塩素」は52 P&G ファブリーズ 車用 無香 130g;ドクターデオプレミアム エアコン取付タイプ ブラックメッキ 無香 メーカー カーメイト 規格/品番 D222 サイズ 重量/容量 内容量:8g おすすめ 従来品比0%アップの消臭性能を実現 除菌消臭成分に安定化二酸化塩素を採用
DrDEO (ドクターデオ)とは ドクターデオは「安定化二酸化塩素」を採用し、イヤなニオイを消臭するだけでなく、空気中の菌・ウイルスを除去し、快適な暮らしのための「清潔空間」を作り出します。 ドクターデオの実力は数値としても出ています。 実験特徴 カーメイト carmate DSD31 ドクターデオ お部屋の除菌 エアコン貼付けタイプ DrDEO 除菌 部屋 消臭 ウイルス 菌 無香料 ウイルス対策 ウイルス対策グッズウィルス ウィルス対策 ウィルス対策グッズ 衛生消臭剤 車 二酸化塩素 カーメイト D222 DrDEO プレミアム エアコン取付タイプ ブラックメッキ 無香。消臭剤 車 二酸化塩素 カーメイト D222 DrDEO ドクターデオ プレミアム エアコン取付タイプ ブラックメッキ 無香 安定化二酸化塩素 車の強力消臭除菌剤 carmate
車 消臭 ドクターデオ エアコンのギャラリー
各画像をクリックすると、ダウンロードまたは拡大表示できます
![]() | ![]() | ![]() |
![]() | ![]() | ![]() |
![]() | ![]() | ![]() |
「車 消臭 ドクターデオ エアコン」の画像ギャラリー、詳細は各画像をクリックしてください。
![]() | ![]() | |
![]() | ![]() | |
![]() | ![]() | ![]() |
「車 消臭 ドクターデオ エアコン」の画像ギャラリー、詳細は各画像をクリックしてください。
![]() | ![]() | |
![]() | ![]() | ![]() |
![]() | ![]() | ![]() |
「車 消臭 ドクターデオ エアコン」の画像ギャラリー、詳細は各画像をクリックしてください。
![]() | ![]() | ![]() |
![]() | ![]() | ![]() |
![]() | ||
「車 消臭 ドクターデオ エアコン」の画像ギャラリー、詳細は各画像をクリックしてください。
![]() | ![]() | ![]() |
![]() | ![]() | ![]() |
![]() | ![]() | ![]() |
「車 消臭 ドクターデオ エアコン」の画像ギャラリー、詳細は各画像をクリックしてください。
![]() | ![]() | |
![]() | ![]() | ![]() |
![]() | ![]() | ![]() |
「車 消臭 ドクターデオ エアコン」の画像ギャラリー、詳細は各画像をクリックしてください。
![]() | ![]() | ![]() |
![]() | ![]() | ![]() |
![]() | ![]() | ![]() |
「車 消臭 ドクターデオ エアコン」の画像ギャラリー、詳細は各画像をクリックしてください。
![]() | ![]() | ![]() |
![]() | ||
![]() | ![]() | ![]() |
「車 消臭 ドクターデオ エアコン」の画像ギャラリー、詳細は各画像をクリックしてください。
![]() | ![]() | ![]() |
![]() | ![]() | |
![]() | ![]() | |
「車 消臭 ドクターデオ エアコン」の画像ギャラリー、詳細は各画像をクリックしてください。
![]() | ![]() | ![]() |
![]() | ![]() | ![]() |
![]() | ![]() | |
「車 消臭 ドクターデオ エアコン」の画像ギャラリー、詳細は各画像をクリックしてください。
![]() | ||
![]() | ![]() | ![]() |
![]() | ![]() | |
「車 消臭 ドクターデオ エアコン」の画像ギャラリー、詳細は各画像をクリックしてください。
![]() | ![]() | |
![]() |
消臭剤 エアコン 車 カーメイト D172 ドクターデオ DrDEO エアコンスプレータイプ 車の強力消臭除菌 消臭スプレー 除菌 無香 安定化二酸化塩素 迅速な対応で商品をお届け致します carmate 車の強力消臭剤 840円 消臭剤 エアコン 車 カーメイト D172 ドクターデオ Dr ドクターデオ エアコンスプレータイプ 最後にエアコン用ドクターデオを使いたいと思います。使用前にエンジンをかけて、吹き出し口をベント(顔に向けての噴射)に変更し、内気循環に設定。ファンスイッチをオフにして、窓を必ず開けた状態でエンジンを切ります。 続いてエアコン
Incoming Term: 車 消臭 ドクターデオ エアコン,

コメント
コメントを投稿